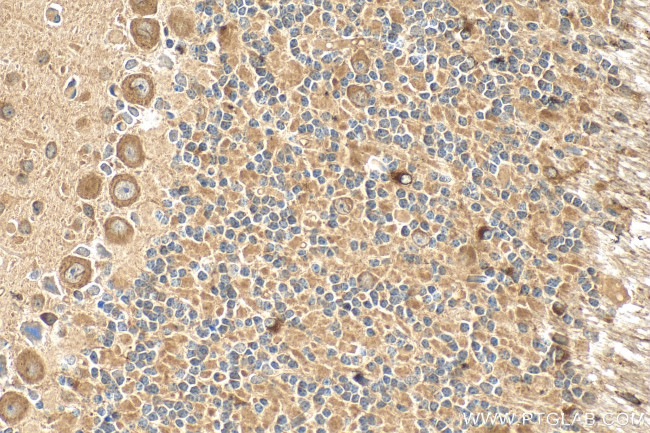
CDIPT Antibody in Immunohistochemistry (Paraffin) (IHC (P))

Search
Proteintech
CDIPT Polyclonal Antibody
{{$productOrderCtrl.translations['antibody.pdp.commerceCard.promotion.promotions']}}
{{$productOrderCtrl.translations['antibody.pdp.commerceCard.promotion.viewpromo']}}
{{$productOrderCtrl.translations['antibody.pdp.commerceCard.promotion.promocode']}}: {{promo.promoCode}} {{promo.promoTitle}} {{promo.promoDescription}}. {{$productOrderCtrl.translations['antibody.pdp.commerceCard.promotion.learnmore']}}
产品信息
22465-1-AP
种属反应
宿主/亚型
分类
类型
抗原
偶联物
形式
浓度
规格
纯化类型
保存液
内含物
保存条件
运输条件
产品详细信息
Immunogen sequence: LYPGATLFFQ ISMSLDVASH WLHLHSSVVR GSESHKMIDL SGNPVLRIYY TSRPALFTLC AGNEL
靶标信息
CDIPT is a protein which is phosphatidylinositol breakdown products that are ubiquitous second messengers that function downstream of many G protein-coupled receptors and tyrosine kinases regulating cell growth, calcium metabolism, and protein kinase C activity. Two enzymes, CDP-diacylglycerol synthase and phosphatidylinositol synthase, are involved in the biosynthesis of phosphatidylinositol. Phosphatidylinositol synthase, a member of the CDP-alcohol phosphatidyl transferase class-I family, is an integral membrane protein found on the cytoplasmic side of the endoplasmic reticulum and the Golgi apparatus.
仅用于科研。不用于诊断过程。未经明确授权不得转售。
篇参考文献 (0)
生物信息学
蛋白别名: CDP-diacylglycerol--inositol 3-phosphatidyltransferase; Phosphatidylinositol synthase; PI synthase; ptdIns synthase
基因别名: 9530042F15Rik; Cdipt; D7Bwg0575e; Pis; Pis1
UniProt ID: (Mouse) Q8VDP6
Entrez Gene ID: (Mouse) 52858